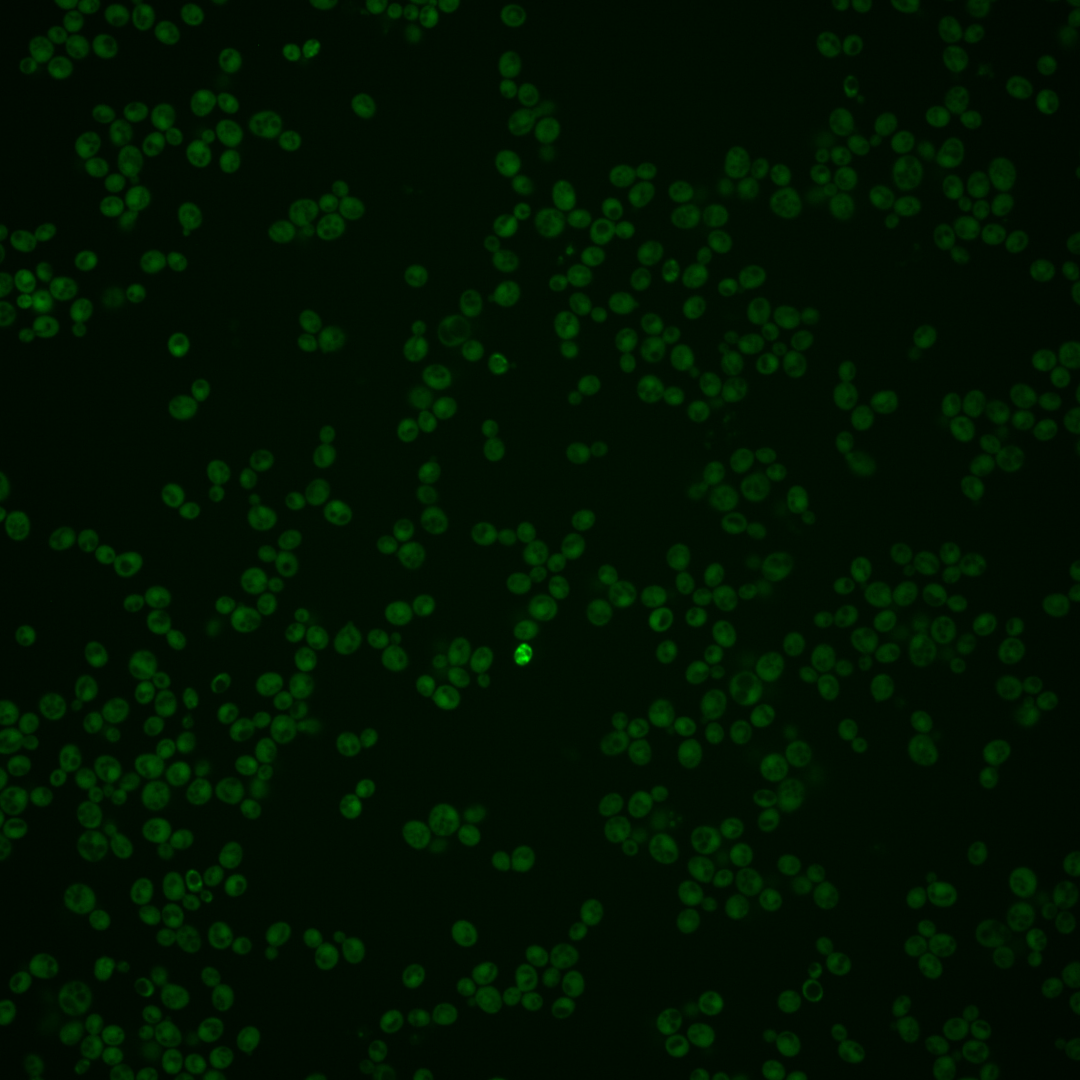
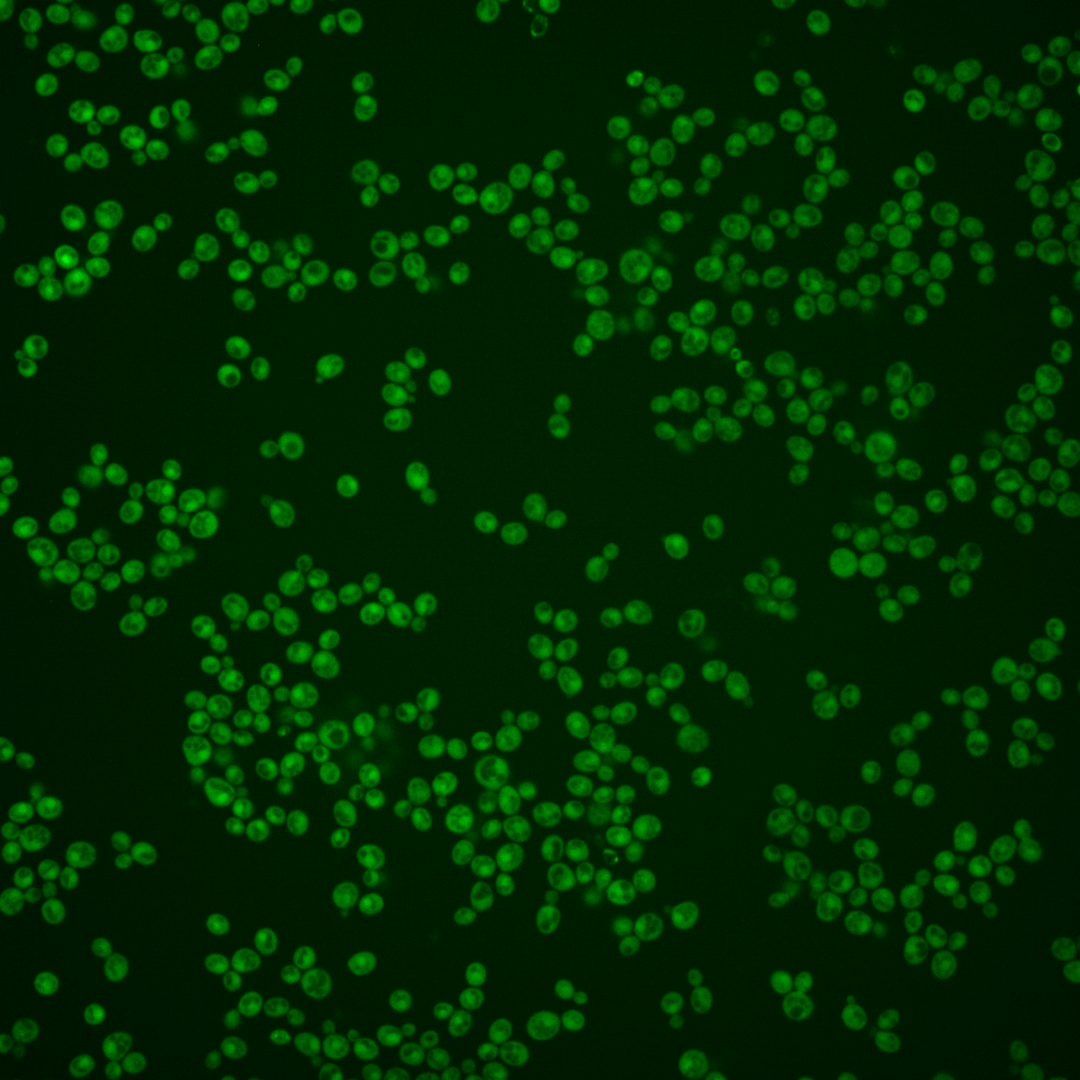

| Standard name | |
|---|---|
| Human Ortholog | |
| Description | Negative regulator of actin nucleation-promoting factor activity; interacts with Las17p, a homolog of human Wiskott-Aldrich Syndrome protein (WASP), via an N-terminal SH3 domain, and along with LSB1 cooperatively inhibits the nucleation of actin filaments; short-lived protein whose levels increase in response to thermal stress; induces the formation of the [PIN+] and [RNQ+] prions when overproduced; PIN3 has a paralog, LSB1, that arose from the whole genome duplication |
Micrographs




















































































Sub-cellular Localization
Yeast GFP Assignment
Protein Abundance
Localization Change
External localization resources
| ensLOC | DeepLoc | |||||||||||||||||||||||
|---|---|---|---|---|---|---|---|---|---|---|---|---|---|---|---|---|---|---|---|---|---|---|---|---|
| Localization | WT1 | WT2 | WT3 | RAP60 | RAP140 | RAP220 | RAP300 | RAP380 | RAP460 | RAP540 | RAP620 | RAP700 | HU80 | HU120 | HU160 | rpd3Δ_1 | rpd3Δ_2 | rpd3Δ_3 | WT1 | WT2 | WT3 | AF100 | AF140 | AF180 |
| Cortical Patches | 0 | 0 | 0 | 0 | 0 | 1 | 0 | 1 | 0 | 1 | 0 | 0 | 0 | 0 | 0 | 0 | 0 | 0 | 1 | 3 | 0 | 0 | 2 | 2 |
| Bud | 0 | 0 | 0 | 0 | 0 | 3 | 0 | 1 | 1 | 1 | 2 | 0 | 0 | 0 | 0 | 0 | 1 | 0 | 0 | 0 | 3 | 0 | 2 | 8 |
| Bud Neck | 0 | 0 | 0 | 0 | 0 | 0 | 0 | 0 | 0 | 0 | 0 | 0 | 0 | 0 | 0 | 0 | 0 | 0 | 0 | 1 | 0 | 0 | 0 | 0 |
| Bud Site | 0 | 0 | 0 | 0 | 0 | 0 | 0 | 0 | 0 | 0 | 0 | 0 | 0 | 0 | 0 | 0 | 0 | 0 | – | – | – | – | – | – |
| Cell Periphery | 0 | 0 | 5 | 2 | 3 | 1 | 3 | 8 | 2 | 7 | 8 | 7 | 1 | 1 | 2 | 4 | 4 | 4 | 0 | 0 | 0 | 0 | 0 | 0 |
| Cytoplasm | 161 | 330 | 188 | 185 | 269 | 138 | 209 | 244 | 174 | 203 | 149 | 140 | 315 | 407 | 422 | 178 | 179 | 175 | 161 | 310 | 182 | 308 | 341 | 378 |
| Endoplasmic Reticulum | 1 | 6 | 2 | 1 | 3 | 1 | 2 | 1 | 1 | 4 | 4 | 7 | 6 | 0 | 1 | 5 | 2 | 5 | 1 | 2 | 0 | 1 | 6 | 8 |
| Endosome | 0 | 0 | 1 | 0 | 0 | 0 | 0 | 1 | 0 | 0 | 1 | 1 | 0 | 0 | 0 | 0 | 0 | 0 | 3 | 3 | 1 | 0 | 3 | 14 |
| Golgi | 1 | 1 | 0 | 0 | 0 | 0 | 0 | 0 | 1 | 0 | 0 | 0 | 0 | 0 | 0 | 1 | 2 | 1 | 2 | 1 | 0 | 1 | 2 | 2 |
| Mitochondria | 3 | 1 | 0 | 3 | 1 | 18 | 6 | 17 | 10 | 27 | 21 | 26 | 1 | 0 | 0 | 7 | 3 | 2 | 1 | 3 | 0 | 0 | 1 | 0 |
| Nucleus | 0 | 2 | 1 | 1 | 1 | 4 | 4 | 6 | 3 | 13 | 6 | 9 | 4 | 1 | 0 | 4 | 5 | 3 | 0 | 3 | 2 | 2 | 2 | 4 |
| Nuclear Periphery | 0 | 1 | 0 | 0 | 0 | 0 | 0 | 0 | 0 | 2 | 1 | 2 | 0 | 0 | 0 | 0 | 0 | 0 | 1 | 0 | 0 | 0 | 0 | 4 |
| Nucleolus | 0 | 0 | 0 | 0 | 0 | 0 | 0 | 0 | 0 | 0 | 0 | 1 | 0 | 0 | 0 | 3 | 0 | 0 | 0 | 0 | 0 | 0 | 0 | 0 |
| Peroxisomes | 0 | 0 | 0 | 0 | 0 | 0 | 0 | 0 | 0 | 0 | 0 | 0 | 0 | 0 | 0 | 0 | 0 | 0 | 0 | 1 | 0 | 0 | 0 | 0 |
| SpindlePole | 0 | 0 | 0 | 0 | 0 | 0 | 0 | 0 | 0 | 0 | 0 | 0 | 0 | 0 | 0 | 1 | 0 | 0 | 0 | 0 | 0 | 0 | 2 | 4 |
| Vac/Vac Membrane | 4 | 1 | 5 | 17 | 81 | 12 | 73 | 112 | 50 | 61 | 35 | 40 | 3 | 18 | 20 | 38 | 19 | 17 | 2 | 4 | 0 | 4 | 3 | 4 |
| Unique Cell Count | 169 | 338 | 194 | 205 | 323 | 166 | 267 | 366 | 233 | 290 | 208 | 206 | 322 | 418 | 437 | 211 | 200 | 190 | 179 | 340 | 194 | 327 | 373 | 441 |
| Labelled Cell Count | 170 | 342 | 202 | 209 | 358 | 178 | 297 | 391 | 242 | 319 | 227 | 233 | 330 | 427 | 445 | 241 | 215 | 207 | 179 | 340 | 194 | 327 | 373 | 441 |
Yeast GFP Assignment
Protein Abundance
| Screen | WT1 | WT2 | WT3 | RAP60 | RAP140 | RAP220 | RAP300 | RAP380 | RAP460 | RAP540 | RAP620 | RAP700 | HU80 | HU120 | HU160 | rpd3Δ_1 | rpd3Δ_2 | rpd3Δ_3 | AF100 | AF140 | AF180 |
|---|---|---|---|---|---|---|---|---|---|---|---|---|---|---|---|---|---|---|---|---|---|
| Mean Cell GFP Intensity (1e-4) | 8.7 | 9.8 | 9.9 | 9.5 | 11.1 | 7.1 | 9.9 | 9.7 | 9.0 | 9.0 | 9.0 | 8.6 | 9.3 | 10.6 | 10.9 | 16.8 | 16.2 | 15.2 | 8.8 | 10.1 | 11.1 |
| Std Deviation (1e-4) | 1.2 | 1.8 | 1.7 | 1.5 | 1.7 | 1.7 | 2.2 | 1.9 | 2.3 | 2.1 | 2.4 | 2.0 | 1.9 | 2.0 | 1.9 | 6.1 | 5.2 | 5.8 | 1.8 | 2.0 | 2.3 |
| Intensity Change (Log2) | – | – | – | -0.07 | 0.16 | -0.49 | -0.01 | -0.04 | -0.15 | -0.15 | -0.15 | -0.2 | -0.09 | 0.1 | 0.14 | 0.75 | 0.71 | 0.61 | -0.17 | 0.02 | 0.16 |
Localization Change
| Localization | RAP60 | RAP140 | RAP220 | RAP300 | RAP380 | RAP460 | RAP540 | RAP620 | RAP700 | HU80 | HU120 | HU160 | rpd3Δ_1 | rpd3Δ_2 | rpd3Δ_3 |
|---|---|---|---|---|---|---|---|---|---|---|---|---|---|---|---|
| Cortical Patches | 0 | 0 | 0 | 0 | 0 | 0 | 0 | 0 | 0 | 0 | 0 | 0 | 0 | 0 | 0 |
| Bud | 0 | 0 | 0 | 0 | 0 | 0 | 0 | 0 | 0 | 0 | 0 | 0 | 0 | 0 | 0 |
| Bud Neck | 0 | 0 | 0 | 0 | 0 | 0 | 0 | 0 | 0 | 0 | 0 | 0 | 0 | 0 | 0 |
| Bud Site | 0 | 0 | 0 | 0 | 0 | 0 | 0 | 0 | 0 | 0 | 0 | 0 | 0 | 0 | 0 |
| Cell Periphery | 0 | 0 | 0 | 0 | 0 | 0 | 0 | 0.7 | 0.5 | 0 | 0 | 0 | 0 | 0 | 0 |
| Cytoplasm | -2.7 | -4.7 | -4.5 | -5.7 | -8.1 | -6.4 | -7.4 | -6.9 | -7.5 | 0.6 | 0.3 | -0.2 | -4.3 | -2.9 | -2.1 |
| Endoplasmic Reticulum | 0 | 0 | 0 | 0 | 0 | 0 | 0 | 0 | 0 | 0 | 0 | 0 | 0 | 0 | 0 |
| Endosome | 0 | 0 | 0 | 0 | 0 | 0 | 0 | 0 | 0 | 0 | 0 | 0 | 0 | 0 | 0 |
| Golgi | 0 | 0 | 0 | 0 | 0 | 0 | 0 | 0 | 0 | 0 | 0 | 0 | 0 | 0 | 0 |
| Mitochondria | 0 | 0 | 4.7 | 0 | 3.0 | 0 | 4.4 | 4.5 | 5.1 | 0 | 0 | 0 | 0 | 0 | 0 |
| Nucleus | 0 | 0 | 0 | 0 | 0 | 0 | 2.6 | 0 | 0 | 0 | 0 | 0 | 0 | 0 | 0 |
| Nuclear Periphery | 0 | 0 | 0 | 0 | 0 | 0 | 0 | 0 | 0 | 0 | 0 | 0 | 0 | 0 | 0 |
| Nucleolus | 0 | 0 | 0 | 0 | 0 | 0 | 0 | 0 | 0 | 0 | 0 | 0 | 0 | 0 | 0 |
| Peroxisomes | 0 | 0 | 0 | 0 | 0 | 0 | 0 | 0 | 0 | 0 | 0 | 0 | 0 | 0 | 0 |
| SpindlePole | 0 | 0 | 0 | 0 | 0 | 0 | 0 | 0 | 0 | 0 | 0 | 0 | 0 | 0 | 0 |
| Vacuole | 2.5 | 6.7 | 2.1 | 7.0 | 7.8 | 5.8 | 5.8 | 4.8 | 5.3 | 0 | 1.0 | 1.2 | 5.0 | 2.9 | 2.7 |
External localization resources
Images






























Protein Concentration and Protein Localization Data
| R1 | R2 | R3 | ||||||||||||||||
|---|---|---|---|---|---|---|---|---|---|---|---|---|---|---|---|---|---|---|
| G1 Pre-START | G1 Post-START | S/G2 | Metaphase | Anaphase | Telophase | G1 Pre-START | G1 Post-START | S/G2 | Metaphase | Anaphase | Telophase | G1 Pre-START | G1 Post-START | S/G2 | Metaphase | Anaphase | Telophase | |
| Concentration | 3.8839 | 5.3711 | 4.1951 | 3.4719 | 3.591 | 4.1487 | 5.5378 | 7.1806 | 6.1087 | 5.1042 | 5.767 | 6.1453 | 7.9033 | 9.8486 | 8.5967 | 8.8534 | 8.211 | 8.5948 |
| Actin | 0.0336 | 0.0024 | 0.0218 | 0.0323 | 0.0302 | 0.0059 | 0.0324 | 0.0035 | 0.0285 | 0.0849 | 0.046 | 0.0057 | 0.0594 | 0.0012 | 0.0276 | 0.0027 | 0.0256 | 0.0034 |
| Bud | 0.0009 | 0.0131 | 0.0036 | 0.0012 | 0.002 | 0.001 | 0.0011 | 0.0001 | 0.0021 | 0.0015 | 0.0003 | 0.0003 | 0.0008 | 0.0001 | 0.0007 | 0.0005 | 0.0015 | 0.0001 |
| Bud Neck | 0.0051 | 0.0006 | 0.0023 | 0.0025 | 0.0048 | 0.0035 | 0.0025 | 0.0003 | 0.0022 | 0.002 | 0.0011 | 0.0019 | 0.008 | 0.0003 | 0.0049 | 0.0009 | 0.0011 | 0.0018 |
| Bud Periphery | 0.0008 | 0.0028 | 0.0015 | 0.0016 | 0.0022 | 0.0005 | 0.0021 | 0 | 0.0022 | 0.002 | 0.0004 | 0.0002 | 0.0014 | 0 | 0.0012 | 0.0002 | 0.0013 | 0.0001 |
| Bud Site | 0.0035 | 0.0119 | 0.0084 | 0.0024 | 0.0048 | 0.0002 | 0.0027 | 0.0017 | 0.0164 | 0.0013 | 0.0009 | 0.0002 | 0.0079 | 0.0005 | 0.0059 | 0.0008 | 0.0004 | 0.0001 |
| Cell Periphery | 0.0002 | 0.0003 | 0.0005 | 0.0003 | 0.0003 | 0.0001 | 0.0002 | 0.0001 | 0.0008 | 0.0002 | 0.0001 | 0 | 0.0012 | 0.0001 | 0.0012 | 0.0001 | 0.0001 | 0.0001 |
| Cytoplasm | 0.7266 | 0.911 | 0.8656 | 0.808 | 0.7237 | 0.9002 | 0.8279 | 0.9776 | 0.8553 | 0.8541 | 0.8743 | 0.9126 | 0.8438 | 0.9823 | 0.9048 | 0.9556 | 0.895 | 0.9443 |
| Cytoplasmic Foci | 0.0425 | 0.0138 | 0.0203 | 0.016 | 0.0285 | 0.0231 | 0.0271 | 0.0036 | 0.01 | 0.0027 | 0.0094 | 0.0125 | 0.005 | 0.0015 | 0.0042 | 0.0078 | 0.0034 | 0.0026 |
| Eisosomes | 0.0003 | 0 | 0.0005 | 0.0003 | 0.0013 | 0 | 0.0001 | 0.0001 | 0.0003 | 0.0003 | 0.0002 | 0 | 0.0007 | 0 | 0.0009 | 0 | 0.0001 | 0.0002 |
| Endoplasmic Reticulum | 0.008 | 0.0015 | 0.005 | 0.0048 | 0.0061 | 0.0033 | 0.0025 | 0.0011 | 0.003 | 0.0017 | 0.0062 | 0.0027 | 0.007 | 0.0012 | 0.0038 | 0.0025 | 0.0065 | 0.0035 |
| Endosome | 0.0472 | 0.0015 | 0.0103 | 0.019 | 0.0471 | 0.0104 | 0.0223 | 0.0006 | 0.0163 | 0.007 | 0.0063 | 0.0105 | 0.008 | 0.0002 | 0.003 | 0.0026 | 0.0117 | 0.003 |
| Golgi | 0.015 | 0.0003 | 0.0036 | 0.0178 | 0.0178 | 0.0018 | 0.0122 | 0.0003 | 0.0139 | 0.0157 | 0.004 | 0.0058 | 0.0031 | 0.0001 | 0.0018 | 0.0004 | 0.0021 | 0.0008 |
| Lipid Particles | 0.0164 | 0.0001 | 0.0025 | 0.0058 | 0.0129 | 0.0016 | 0.009 | 0.0007 | 0.0057 | 0.0019 | 0.0096 | 0.0041 | 0.0013 | 0 | 0.0021 | 0.0004 | 0.0016 | 0.0005 |
| Mitochondria | 0.0056 | 0.0006 | 0.0052 | 0.0212 | 0.0113 | 0.0035 | 0.0104 | 0.0002 | 0.0135 | 0.0075 | 0.0011 | 0.0048 | 0.0015 | 0.0001 | 0.0012 | 0.0002 | 0.0031 | 0.0009 |
| None | 0.0248 | 0.015 | 0.0169 | 0.032 | 0.0347 | 0.0115 | 0.0167 | 0.0052 | 0.0074 | 0.0035 | 0.0057 | 0.0127 | 0.0245 | 0.0059 | 0.0263 | 0.0042 | 0.0078 | 0.0152 |
| Nuclear Periphery | 0.0119 | 0.0016 | 0.0032 | 0.0076 | 0.0128 | 0.0067 | 0.0029 | 0.0006 | 0.0016 | 0.0011 | 0.0025 | 0.0016 | 0.0083 | 0.0007 | 0.0018 | 0.0028 | 0.021 | 0.0054 |
| Nucleolus | 0.0005 | 0.0003 | 0.0005 | 0.0004 | 0.003 | 0.0001 | 0.0003 | 0 | 0.0024 | 0.0001 | 0.0002 | 0 | 0.0005 | 0 | 0.0002 | 0.0001 | 0.0005 | 0.0007 |
| Nucleus | 0.0214 | 0.0172 | 0.0163 | 0.0169 | 0.0244 | 0.0149 | 0.015 | 0.0032 | 0.0103 | 0.0099 | 0.0053 | 0.009 | 0.0083 | 0.0052 | 0.0057 | 0.0104 | 0.0086 | 0.0146 |
| Peroxisomes | 0.0223 | 0.0032 | 0.0057 | 0.002 | 0.0073 | 0.0041 | 0.007 | 0.0004 | 0.0031 | 0.0006 | 0.0192 | 0.0137 | 0.0008 | 0 | 0.0005 | 0.0002 | 0.0005 | 0.0001 |
| Punctate Nuclear | 0.0096 | 0.002 | 0.0042 | 0.0057 | 0.0198 | 0.0058 | 0.0025 | 0.0003 | 0.0019 | 0.0005 | 0.006 | 0.001 | 0.0073 | 0.0003 | 0.001 | 0.0071 | 0.0063 | 0.002 |
| Vacuole | 0.0023 | 0.0007 | 0.0017 | 0.0015 | 0.0034 | 0.0014 | 0.0018 | 0.0003 | 0.0021 | 0.0008 | 0.0009 | 0.0003 | 0.0008 | 0.0002 | 0.0009 | 0.0005 | 0.0009 | 0.0004 |
| Vacuole Periphery | 0.0014 | 0.0001 | 0.0004 | 0.0009 | 0.0015 | 0.0004 | 0.001 | 0 | 0.0009 | 0.0006 | 0.0002 | 0.0003 | 0.0005 | 0 | 0.0002 | 0.0001 | 0.0008 | 0.0004 |
Sequencing Data
| R1 | R2 | |||||||||
|---|---|---|---|---|---|---|---|---|---|---|
| G1 Post-START | S/G2 | Metaphase | Anaphase | Telophase | G1 Post-START | S/G2 | Metaphase | Anaphase | Telophase | |
| Gene Expression | 40.8668 | 24.355 | 33.8858 | 46.7354 | 26.4928 | 44.2479 | 50.7896 | 59.2102 | 44.463 | 47.7991 |
| Translational Efficiency | 2.184 | 3.1075 | 1.8488 | 1.0241 | 2.5955 | 2.958 | 1.9678 | 1.8235 | 2.3387 | 1.8345 |
Hit Data
| Dataset | Hit |
|---|---|
| Protein Concentration | ✘ |
| Protein Localization | ✘ |
| Gene Expression | ✘ |
| Translational Efficiency | ✘ |
Endocytosis
| Temp | Actin Patch (Sac6-tdTomato) | Cortical Patch (Sla1-GFP) | Late Endosome (Snf7-GFP) | Vacuole (Vph1-GFP) |
|---|---|---|---|---|
| 37℃ | ||||
| RT |
Cell Cycle Omics
CYCLoPs (Pin3-GFP)
| Gene / Allele | Actin Patch (Sac6-tdTomato) | Cortical Patch (Sla1-GFP) | Late Endosome (Snf7-GFP) | Vacuole (Sac6-tdTomato) |
|---|
| Gene | Images |
|---|
| Gene | Images |
|---|
Images are not yet available
Images are not yet available